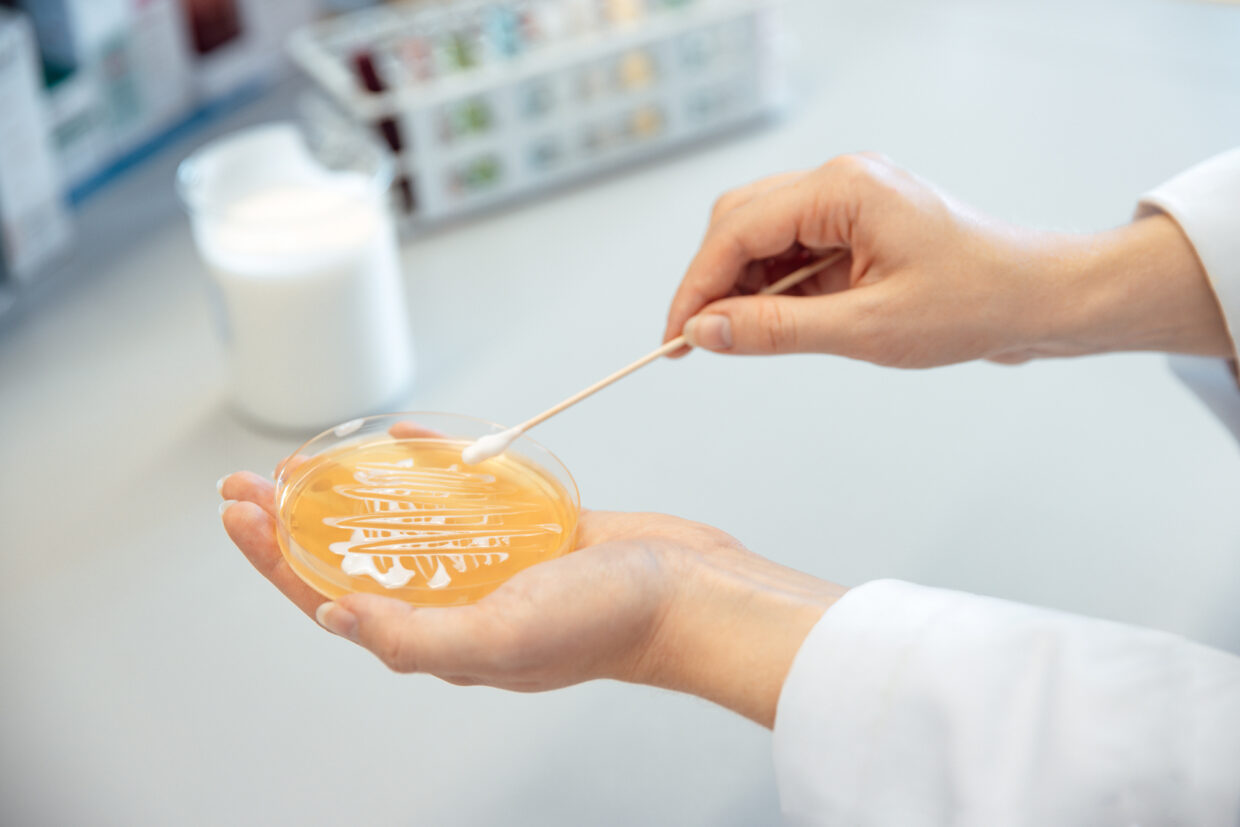
WEB_11A7398_Annemarie-Boerlind_Location_Sven-Cichowicz_2021 - Deutsche Manufakturenstrasse Hände in einem Labor, die mit einem Wattestäbchen eine Petri-Schale mit orangefarbener Kultur befeuchten.

Zwischen Schwarzwaldrosen, Fackellilien und Ringelblumen entspringt aus 166 Metern Tiefe die Schwarzwälder Tiefenquelle des Walter-Lindner-Brunnens. Ihr reines und weiches Wasser findet sich in den Produkten von Annemarie Börlind wieder.
Das Familienunternehmen in dritter Generation, welches 1959 von Annemarie Lindner gegründet wurde, setzt bei der Herstellung ihrer Naturkosmetik auf vegane und vegetarische Inhaltsstoffe.
Um Ressourcen zu schonen werden teils naturidentische Stoffe eingesetzt, um so bedrohte Pflanzenarten nicht durch kommerzielle Nutzung weiter zu gefährden. Die verwendeten Pflanzen stammen überwiegend aus kontrolliert biologischen Anbau oder aus Wildsammlung und wurden nicht gentechnisch verändert.
Gründerin Annemarie Lindner litt selbst unter Hautproblemen und ergriff schließlich den Beruf der Kosmetikerin, um eigene Pflegeprodukte herzustellen.
Noch heute ist das Kredo von Gründerin Annemarie Lindner prägend für die Philosophie des Unternehmens. „Was ich nicht essen kann, gebe ich nicht auf meine Haut.“ war schon damals ihr Motto. Die Produkte finden sich auf den exklusivsten Einkaufsstraßen weltweit.